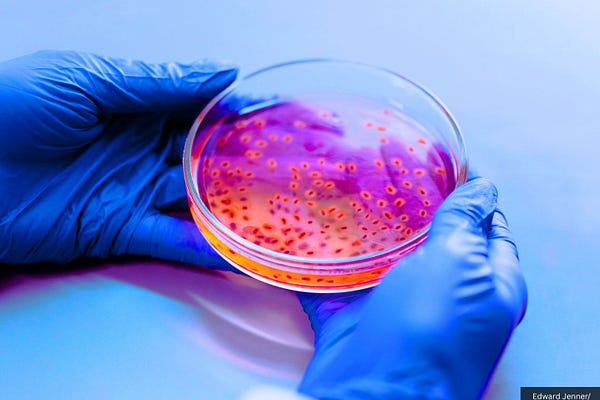

Most Popular
View all

34:46


JonFleetwood.com
Independent research journalism exposing health & political systems weaponized against Americans. Seen on RFK Jr.'s Children's Health Defense, Alex Jones' InfoWars, Russell Brand's podcast, One America News, ZeroHedge, Zeee Media, & Modernity News.
© 2025 Jon Fleetwood
Substack is the home for great culture